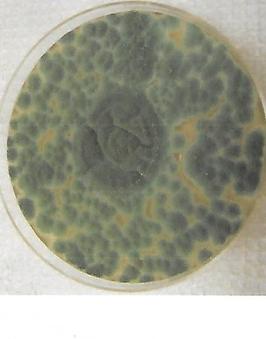
card image
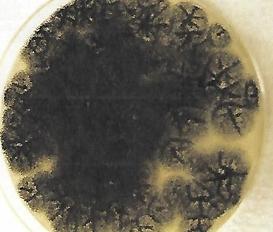
card image
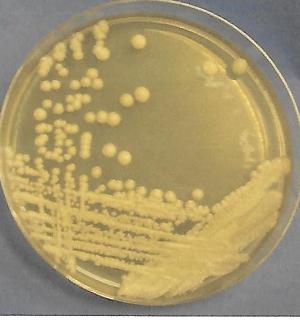
card image
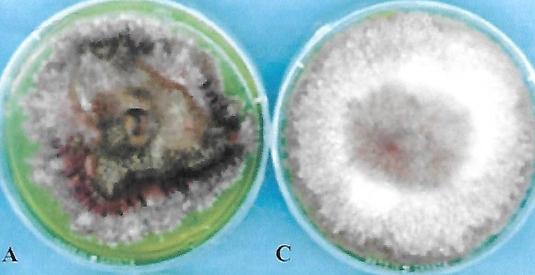
card image
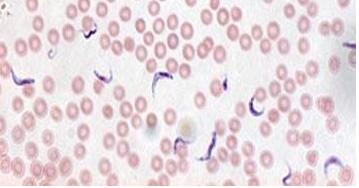
card image
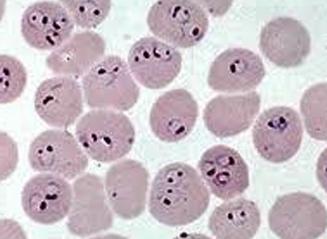
card image

What is the tool used for spreading plates?
Glass spreader or hockey stick
What do we use to inoculate semi-solid media
inoculation needle
Bacteria used in bacteriophage lab
Streptomyces greseus
How do you calculate titer/VCN?
(# of colonies x dilution factor)/mL pipetted
What is a plaque and how are they formed?
A plaque is a clearing in a bacterial lawn caused by a bacteriophage eating the nutrients on the agar and reproducing
What type of plaques are formed in the lysogenic and lytic cycle?
Lysogenic produces cloudy plaques whereas lytic produces clear plaques
Define coliphage and bacteriophage
coliphage: a bacteriophage that specifically infects e.coli
bacteriophage: a virus that infects bacteria
What does PFU stand for?
Plaque forming units
What is an obligate intracellular parasite?
an organism that can only reproduce inside of a host cell
lytic cycle stages
attachment, penetration, biosynthesis, maturation, and lysis
Are coliforms gram negative or positive and what do they ferment?
Gram negative and lactose fermenting rods
Two advantages of colisure test
Quick results: in under 24 hours
color change: easy to interpret
What is the principle indicator organism in fecal contamination
e.coli
wavelength of light used to interpret colisure test
365 nm
Name of enzyme in coliforms (all)?
B-Galactosidase
Name of enzyme in e.coli?
B-Glucuronidase
Principle behind oxidase test
Prescence of enzyme cytochrome c oxidase
Name of indicator in developing oxidase test
TMPD
What organism tested positive for the oxidase test
Pseudomonas Vibrioionaceae
What tested negative for oxidase test
Enterobacteriae
Review Rhizopus on plate
Black and tan and fuzzy
Review Aspergillus on plate
Solid black plate with little white
Media used for growing fungi in lab
SDA: sabouraud dextrose agar
define dimorphic fungi
produce anitbiotics ie.penicillium produces penicillin
What is lichen? How do they help each other?
Algae and fungi engaging in a symbiotic relationship
Algae provides carbohydrates and fungi provides structure, moisture, and protection
Enzyme that detoxifies hydrogen peroxide how do you test for it
Catalase
bubbles
What organism was negative for catalase test? positive?
n= streptococcus species
p= staphlyococcus aureus
What reagent was used for oxidase test
Hydrogen peroxide
Two stages of protozoa
Trophozoite: active, feeding, motile
Cyst: dormant, resistant stage
Two characteristics of protozoa
Unicellular eukaryotes
motile
4 classes of protozoa
Mastigophora: motile using flagella
Ciliophora: motile using cilia
Sarcodina: move using pseudopodia
Apicomplexa: non motile:glide
What reagent in used in developing starch hydrolysis test
grams iodine
Principle behind starch hydrolysis test
Produce amylase to break down starch
Example of mesophile
e.coli
example of thermophile
s. stearothermophile
what is a pandemic and epidemic
Worldwide spread
epi= increased number of cases in a specific area
Pathogen in epidemiology experiment
pseudomonas putida
MMWR?
Morbidity and mortality weekly report from the CDC
p. putida requires what to grow?
toluic acid
What is a pilus? what is a plasmid?
pilus: initiates conjugation by attaching to recipient cell
plasmid: small circular dna molecule that replicates independently of chromosomal dna
plasmid responsible for degrading toluic acid
TOL plasmid

Fusarium: fungi

Rhizopus stolonifer: fungi

Penicillium: fungi

Aspergillus: fungi

Saccaromyces: fungi
Penicillium fungi
Aspergillus niger fungi

Rhizopus stolonifer fungi
Saccaromyces cervisiae fungi
Fusarium fungi

chlamyldomonas algae

Spyrogira algae

Volvox algae

Diatoms algae

Desmids algae

anabaena cyanobacteria

Geleocapsa Cyanobacteria

Oscillatoria cyanobacteria

Spirulina cyanobacteria

Paramecium protozoan

Blepharisma protozoan

Vorticella protozoan

amoeba proto

Euglena proto

Stentor proto
trypanosoma proto
Plasmodium (ring stage) proto

Giardia Lambia

Trichomonas vaginillis proto
auxotroph v prototroph
auxotroph: mutant that cannot synthesize a required nutrient
prototroph: wild-type organism that can synthesize all required nutrients
One use of algae in lab
Agar
Study of algae is called
phycology
two modes of action for antibiotics
inhibiting cell wall synthesis and inhibiting bacterial protein growth
Name of antibiotic susceptibility test? name of media?
Kirby bauer test and the media was mueller hinton agar
advantage of using e-test over kirby bauer test?
Gives exact MIC (minimum inhibtory concentration)
difference between antiseptic and disinfectant?
Antispectic is for living skin, disinfectant is for inanimate surfaces
Structure of importance within fungi
septate hyphae
What is the name of the red pigment produced by serratia marcescens
Prodigiosin